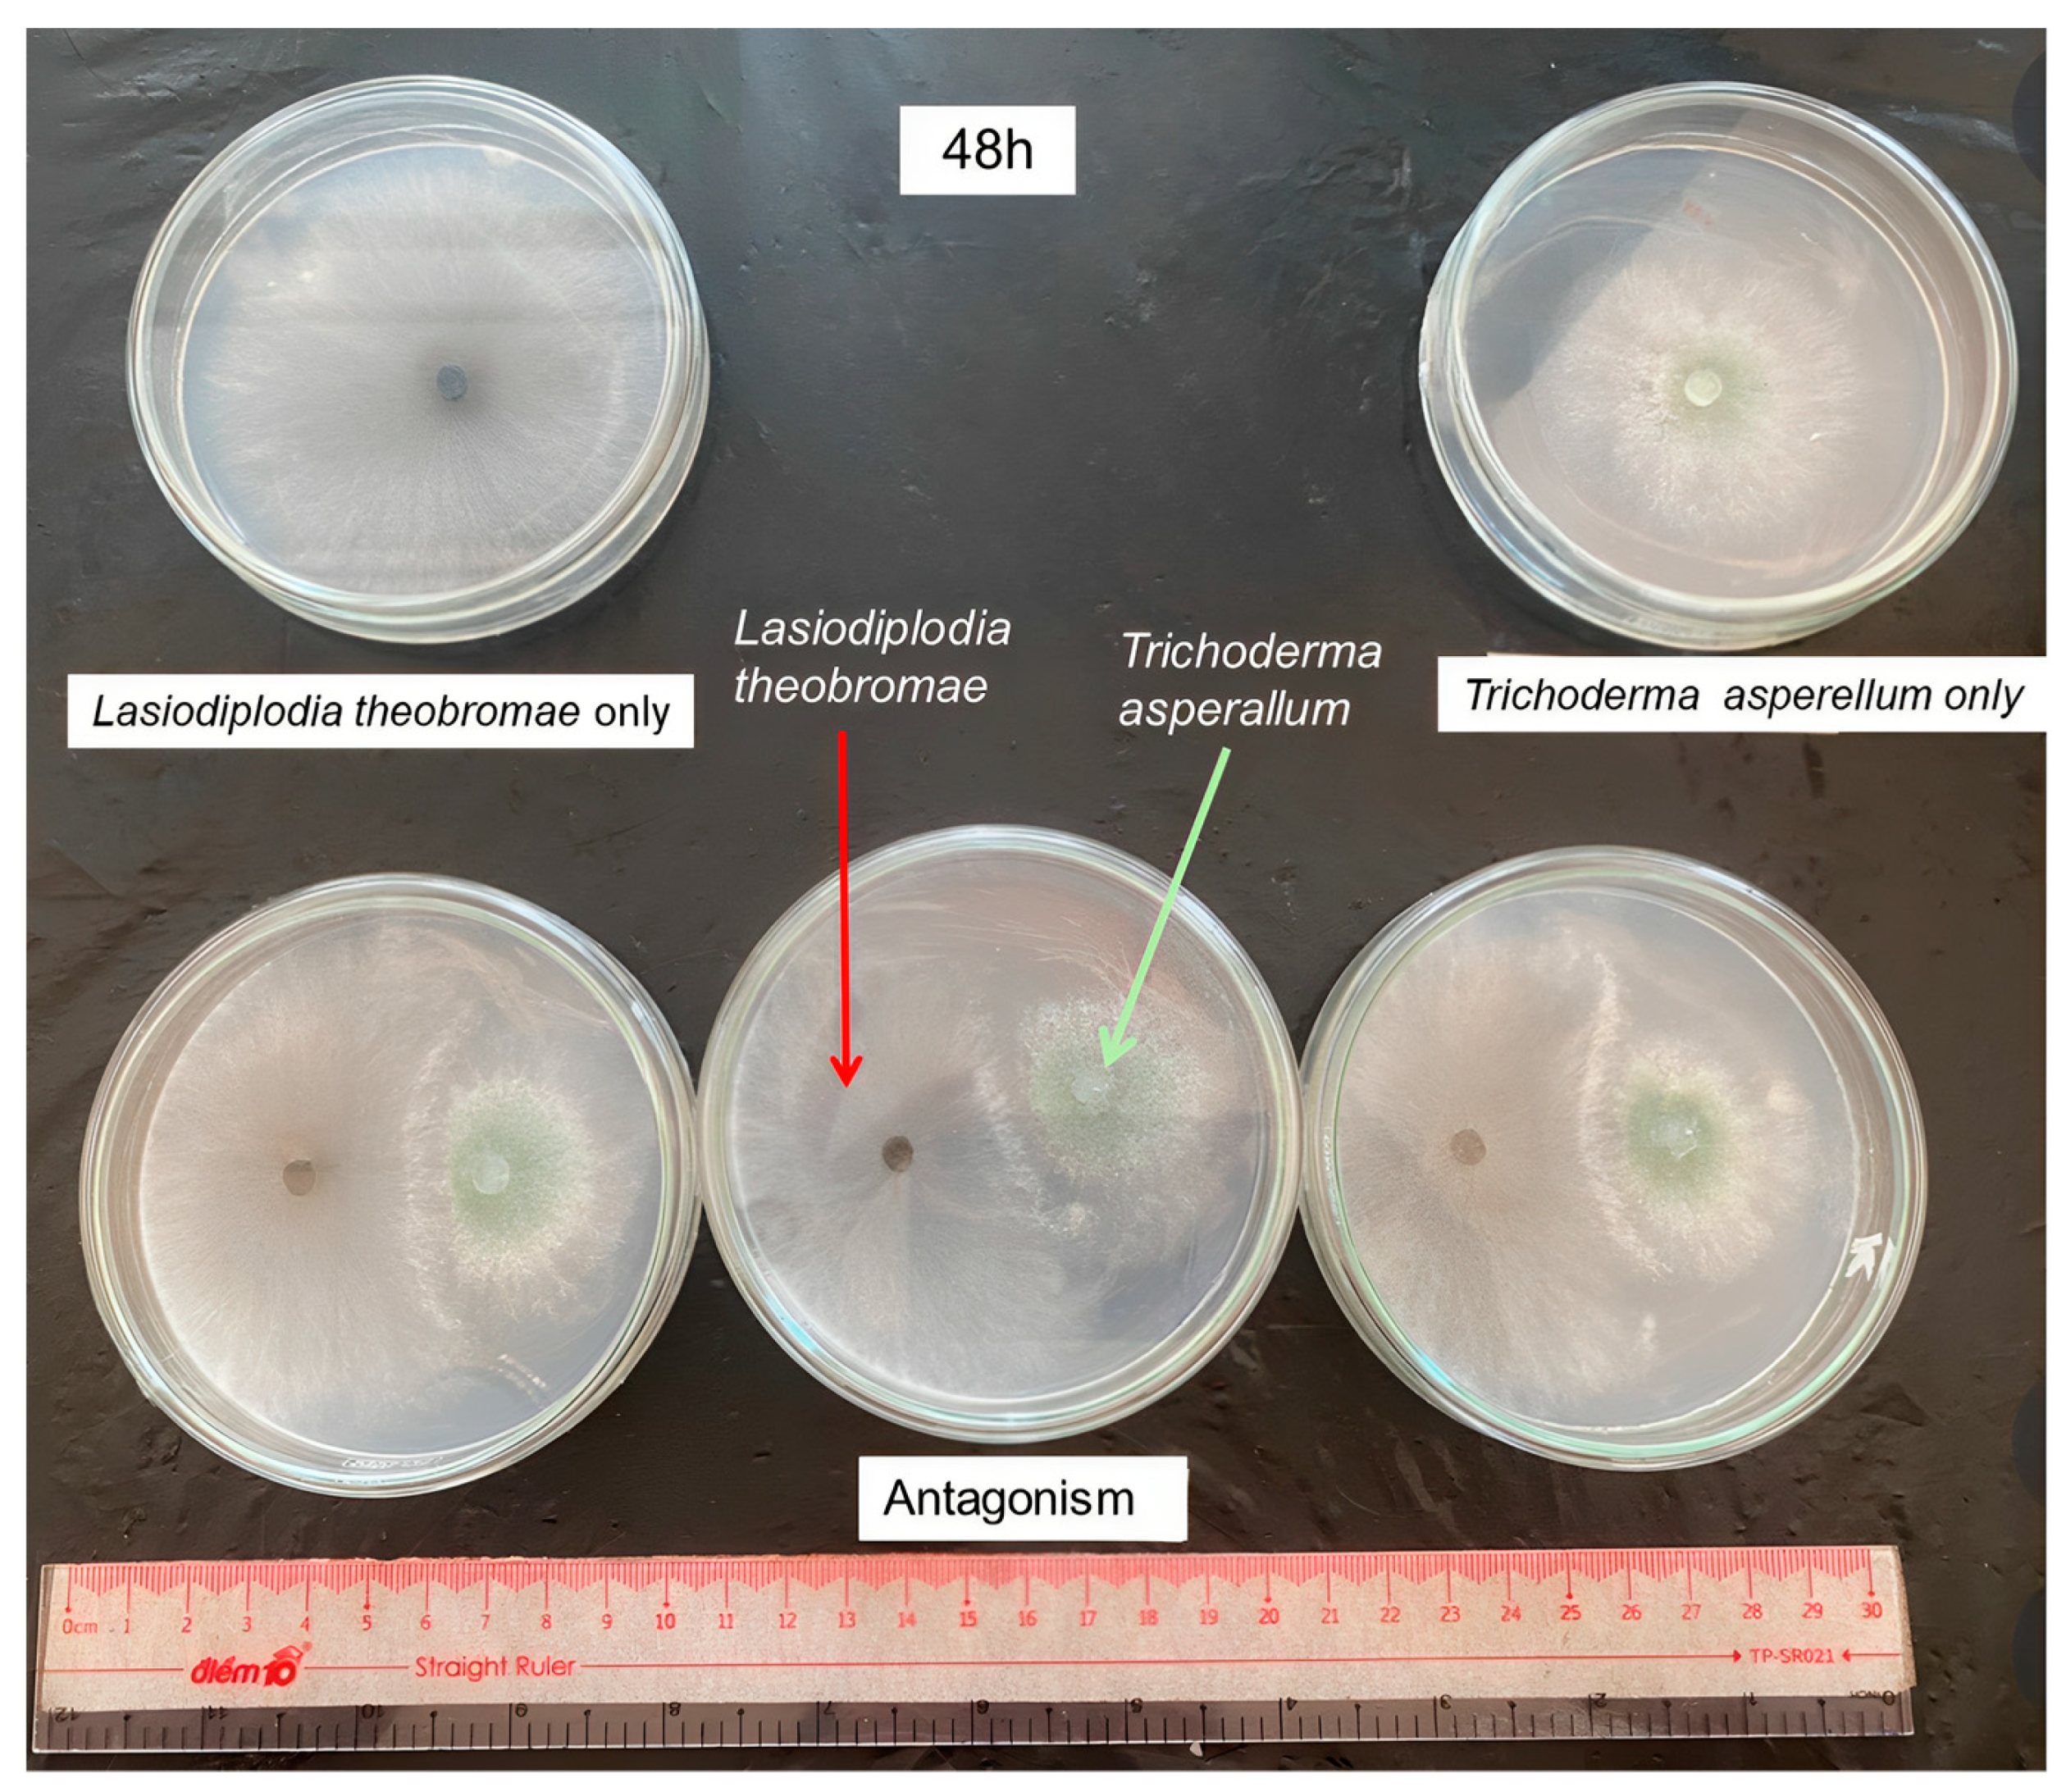
Jof 09 00981 g004a

Using Trichoderma asperellum to Antagonize Lasiodiplodia theobromae Causing Stem-End Rot Disease on Pomelo (Citrus maxima)
Abstract
:1. Introduction
2. Materials and Methods
2.1. Trichoderma spp. Source
2.2. Isolation of Fungal Pathogens
2.3. Evaluation of the Growth Rate of Fungal Pathogens and the Pathogenicity Test
2.4. Evaluation of Antagonistic Activity of Trichoderma spp. against Lasiodiplodia spp. In Vitro Test
- AE is the antagonistic efficiency;
- C is the radius of the pathogenic colony on PDA;
- T is the radius of the pathogenic colony on PDA with Trichoderma spp.
2.5. Identification of the Pathogens and Trichoderma spp.
2.6. Statistical Analysis
3. Results
3.1. Morphological Characteristics of Fungal Pathogen Causing PSERD
3.2. Growth of Fungi Causing PSERD
3.3. Evaluation of the Infection by the Selected Fungi Causing PSERD
3.4. Identification of Selected Pathogens of PSERD
3.5. Antagonistic Activity of Trichoderma Strains against Lasiodiplodia sp.
3.5.1. Antagonistic Activity of Trichoderma sp. against L. theobromae S-P06
3.5.2. Antagonistic Capacity of Trichoderma sp. against L. theobromae S-P07
3.6. Identification of Trichoderma sp. Strains That highly Antagonized the L. theobromae S-P06 and L. theobromae S-P07 Strains
4. Discussion
5. Conclusions
Supplementary Materials
Author Contributions
Funding
Institutional Review Board Statement
Informed Consent Statement
Data Availability Statement
Acknowledgments
Conflicts of Interest
References
- Dissanayake, A.J.; Phillips, A.J.L.; Li, X.H.; Hyde, K.D. Botryosphaeriaceae: Current status of genera and species. Mycosphere 2016, 7, 1001–1073. [Google Scholar] [CrossRef]
- Burgess, T.I.; Tan, Y.P.; Garnas, J.; Edwards, J.; Scarlett, K.A.; Shuttleworth, L.A.; Jami, F. Current status of the Botryosphaeriaceae in Australia. Australas. Plant Pathol. 2019, 48, 35–44. [Google Scholar] [CrossRef]
- Jami, F.; Marincowitz, S.; Durán, A.; Slippers, B.; Abad, J.I.; Chen, S.; Wingfield, M.J. Botryosphaeriaceae diversity on Eucalyptus clones in different climate zones of Indonesia. For. Pathol. 2022, 52, e12737. [Google Scholar] [CrossRef]
- Alves, A.; Crous, P.W.; Correia, A.; Phillips, A.J.L. Morphological and molecular data reveal cryptic speciation in Lasiodiplodia theobromae. Fungal Diver. 2008, 28, 1–13. [Google Scholar]
- Oakeley, H. Modern Medicines from Plants: Botanical Histories of Some of Modern Medicine’s Most Important Drugs; CRC Press: Boca Raton, FL, USA, 2023. [Google Scholar]
- Summerbell, R.C.; Krajden, S.; Levine, R.; Fuksa, M. Subcutaneous phaeohyphomycosis caused by Lasiodiplodia theobromae and successfully treated surgically. Med. Mycol. 2004, 42, 543–547. [Google Scholar] [CrossRef]
- Yildiz, A.; Benlioglu, K.; Benlioglu, H.S. First report of strawberry dieback caused by Lasiodiplodia theobromae. Plant Dis. 2014, 98, 1579. [Google Scholar] [CrossRef] [PubMed]
- Hong, S.K.; Lee, S.Y.; Choi, H.W.; Lee, Y.K.; Joa, J.H.; Shim, H.S. Occurrence of stem-end rot on mango fruits caused by Lasiodiplodia theobromae in Korea. Plant Pathol. J. 2012, 28, 455. [Google Scholar] [CrossRef]
- Salamiah, S. Role of toxin produced by Botryodiplodia theobromae causes diplodia bark diseases on some citrus. J. Trop. Plant Pests Dis. 2009, 9, 158–167. [Google Scholar] [CrossRef]
- Dwiastuti, M.E.; Ketut Budiarta, G.N.; Soesanto, L. Diplodia disease development and toxin of three isolates Botryodiplodia theobromae Path. on Citrus (Citrus spp.). J. Horti. 2018, 27, 231. [Google Scholar] [CrossRef]
- Zhang, J. Lasiodiplodia theobromae in citrus fruit (Diplodia stem-end rot). In Postharvest Decay; Bautista-Baños, S., Ed.; Academic Press: Cambridge, MA, USA, 2014; pp. 309–335. [Google Scholar] [CrossRef]
- Ritenour, M.A.; Zhang, J.; Dewdney, M.M. Control of stem-end rot of fresh citrus. Citrus Ind. 2016, 2016, 12–15. [Google Scholar]
- Zhang, J. Comparative effects of postharvest fungicides for diplodia stem-end rot control of Florida citrus. Proc. Fla. State Hortic. Soc. 2012, 125, 243–247. [Google Scholar]
- Diepenbrock, L.M.; Ritenour, M.A. 2023–2024 Florida Citrus Production Guide: Fresh Fruit Pesticide Residue Limits; IFAS Fact Sheet HS-1301; The Horticultural Sciences Department, UF/IFAS Extension, EDIS: Gainesville, FL, USA, 2023. [Google Scholar] [CrossRef]
- Yan, Z.; Xiong, C.; Liu, H.; Singh, B.K. Sustainable agricultural practices contribute significantly to One Health. J. Sustain. Agric. Environ. 2022, 1, 165–176. [Google Scholar] [CrossRef]
- Zhao, X.; Liu, X.; Zhao, H.; Ni, Y.; Lian, Q.; Qian, H.; He, B.; Liu, H.; Ma, Q. Biological control of Fusarium wilt of sesame by Penicillium bilaiae 47M-1. Bio. Control 2021, 158, 104601. [Google Scholar] [CrossRef]
- Shen, S.S.; Qu, X.Y.; Zhang, W.Z.; Li, J.; Lv, Z.Y. Infection against infection: Parasite antagonism against parasites, viruses and bacteria. Infect. Dis. Poverty 2019, 8, 1–12. [Google Scholar] [CrossRef]
- Chen, J.; Zhou, L.; Din, I.U.; Arafat, Y.; Li, Q.; Wang, J.J.; Wu, T.; Wu, L.; Wu, H.; Qin, X.; et al. Antagonistic activity of Trichoderma spp. against Fusarium oxysporum in rhizosphere of Radix pseudostellariae triggers the expression of host defense genes and improves its growth under long-term monoculture system. Front. Microbiol. 2021, 12, 579920. [Google Scholar] [CrossRef]
- El-Kazzaz, M.K.; Ghoneim, K.E.; Agha, M.K.M.; Helmy, A.; Behiry, S.I.; Abdelkhalek, A.; Saleem, M.H.; Al-Askar, A.A.; Arishi, A.A.; Elsharkawy, M.M. Suppression of pepper root rot and wilt diseases caused by Rhizoctonia solani and Fusarium oxysporum. Life 2022, 12, 587. [Google Scholar] [CrossRef] [PubMed]
- Geng, L.; Fu, Y.; Peng, X.; Yang, Z.; Zhang, M.; Song, Z.; Guo, N.; Chen, S.; Chen, J.; Bai, B.; et al. Biocontrol potential of Trichoderma harzianum against Botrytis cinerea in tomato plants. Biol. Control. 2022, 174, 105019. [Google Scholar] [CrossRef]
- Montalvão, S.C.L.; Marques, E.; Martins, I.; da Silva, J.P.; de Mello, S.C.M. Suppression of the phytopathogens Sclerotinia sclerotiorum and Sclerotium rolfsii by Trichoderma spp. Biologia 2023, 78, 1–12. [Google Scholar] [CrossRef]
- Shah, P.; Abid, M.; Abbas, A.; Basheer, N.; Sheikh, A.H.; Jabeen, N.; Sitara, U. Screening of Trichoderma viride as a bio-control agent against different soil-borne infectious and phytopathogenic fungi. Int. J. Biol. Biotech. 2020, 17, 405–410. [Google Scholar]
- Olowe, O.M.; Nicola, L.; Asemoloye, M.D.; Akanmu, A.O.; Sobowale, A.A.; Babalola, O.O. Characterization and antagonistic potentials of selected rhizosphere Trichoderma species against some Fusarium species. Front. Microbiol. 2022, 13, 985874. [Google Scholar] [CrossRef] [PubMed]
- Li, X.; Leng, J.; Yu, L.; Bai, H.; Li, X.; Wisniewski, M.; Liu, J.; Sui, Y. Efficacy of the biocontrol agent Trichoderma hamatum against Lasiodiplodia theobromae on macadamia. Front. Microbiol. 2022, 13, 994422. [Google Scholar] [CrossRef] [PubMed]
- Wanjiku, E.K.; Waceke, J.W.; Mbaka, J.N. Suppression of stem-end rot on avocado fruit using Trichoderma spp. in the central highlands of Kenya. Adv. Agric. 2021, 2021, 1–6. [Google Scholar] [CrossRef]
- Zhan, X.; Khan, R.A.A.; Zhang, J.; Chen, J.; Yin, Y.; Tang, Z.; Wang, R.; Lu, B.; Liu, T. Control of postharvest stem-end rot on mango by antifungal metabolites of Trichoderma pinnatum LS029-3. Sci. Hortic. 2023, 310, 111696. [Google Scholar] [CrossRef]
- Mourad, A.M.I.; Börner, A.; Esmail, S.M. Alleviation of stripe rust disease in wheat seedlings using three different species of Trichoderma spp. Agriculture 2023, 13, 1755. [Google Scholar] [CrossRef]
- Shivaji, S.; Bhadra, B.; Rao, R.S.; Pradhan, S. Rhodotorula himalayensis sp. nov., a novel psychrophilic yeast isolated from Roopkund Lake of the Himalayan Mountain ranges, India. Extremophiles 2008, 12, 375–381. [Google Scholar] [CrossRef]
- Burgess, L.W.; Knight, T.E.; Tesoriero, L.; Phan, H.T. Diagnostic Manual for Plant Diseases in Vietnam; ACIAR Monograph; ACIAR: Canberra, Australia, 2008; Volume 129, p. 210. [Google Scholar]
- Shivas, R.; Beasley, D. Management of Plant Pathogen Collections; Department of Agriculture, Fisheries and Forestry: Queensland, Australia, 2005; p. 82. [Google Scholar]
- Kakraliya, S.; Choskit, D.; Pandit, D.; Abrol, S. Effect of bioagents, neem leaf extract and fungicides against alternaria leaf blight of wheat (Triticum aestivum L.). Nat. Prod. Chem. Res. 2017, 6, 23–34. [Google Scholar]
- White, T.J.; Bruns, T.; Lee, S.J.W.T.; Taylor, J. Amplification and direct sequencing of fungal ribosomal RNA genes for phylogenetics. In PCR Protocols: A Guide to Methods and Applications; Natvig, D.O., Ed.; Academic Press, Inc.: New York, NY, USA, 1990; Volume 18, pp. 315–322. [Google Scholar]
- Eboigbodin, K.E.; Biggs, C.A. Characterization of the extracellular polymeric substances produced by Escherichia coli using infrared spectroscopic, proteomic, and aggregation studies. Biomacromolecules 2008, 9, 686–695. [Google Scholar] [CrossRef]
- Gnanesh, B.N.; Arunakumar, G.S.; Tejaswi, A.; Supriya, M.; Manojkumar, H.B.; Devi, S.S. Characterization and pathogenicity of Lasiodiplodia theobromae causing black root rot and identification of novel sources of resistance in mulberry collections. Plant Pathol. J. 2022, 38, 272–286. [Google Scholar] [CrossRef] [PubMed]
- Puspita, A.D.; Kuswinanti, T.; Rosmana, A. Analysis of stem rot disease severity on Pomelo (Citrus maxima) plantation in Pangkep Regency, South Sulawesi. IOP Conf. Ser. Earth Environ. Sci. 2023, 1192, 012024. [Google Scholar] [CrossRef]
- Pornsuriya, C.; Thaochan, N.; Chairin, T.; Sunpapao, A. Morphological and phylogenetic evidences reveal Lasiodiplodia chonburiensis and L. theobromae associated with leaf blight in Hevea brasiliensis in Southern Thailand. Diversity 2023, 15, 961. [Google Scholar] [CrossRef]
- Briste, P.S.; Akanda, A.M.; Bhuiyan, M.A.B.; Mahmud, N.U.; Islam, T. Morphomolecular and cultural characteristics and host range of Lasiodiplodia theobromae causing stem canker disease in dragon fruit. J. Basic Microbiol. 2022, 62, 689–700. [Google Scholar] [CrossRef] [PubMed]
- Rahman, M.A. Identification of Lasiodiplodia theobromae ((Pat.) Griff. Maubl) as a causal pathogen of rain tree gummosis (Samanea saman (Jacq.) Merr) and its control management. Bangladesh J. Agric. 2022, 4, 78–96. [Google Scholar] [CrossRef]
- Wu, Q.; Sun, R.; Ni, M.; Yu, J.; Li, Y.; Yu, C.; Dou, K.; Ren, J.; Chen, J. Identification of a novel fungus, Trichoderma asperellum GDFS1009, and comprehensive evaluation of its biocontrol efficacy. PLoS ONE 2017, 12, e0179957. [Google Scholar] [CrossRef] [PubMed]
- Samuels, G.J.; Ismaiel, A.; Bon, M.C.; De Respinis, S.; Petrini, O. Trichoderma asperellum sensu lato consists of two cryptic species. Mycologia 2010, 102, 944–966. [Google Scholar] [CrossRef]
- Cai, F.; Druzhinina, I.S. In honor of John Bissett: Authoritative guidelines on molecular identification of Trichoderma. Fungal Diversity 2021, 107, 1–69. [Google Scholar] [CrossRef]
- Błaszczyk, L.; Popiel, D.; Chełkowski, J.; Koczyk, G.; Samuels, G.J.; Sobieralski, K.; Siwulski, M. Species diversity of Trichoderma in Poland. J. Appl. Genet. 2011, 52, 233–243. [Google Scholar] [CrossRef] [PubMed]
- Chan, M.E.; Tan, J.Y.; Lee, Y.Y.; Lee, D.; Fong, Y.K.; Mutwil, M.; Wong, J.Y.; Hong, Y. Locally isolated Trichoderma harzianum species have broad spectrum biocontrol activities against the wood rot fungal species through both volatile inhibition and mycoparasitism. J. Fungi 2023, 9, 675. [Google Scholar] [CrossRef]
- Morais, E.M.; Silva, A.A.R.; de Sousa, F.W.A.; de Azevedo, I.M.B.; Silva, H.F.; Santos, A.M.G.; Beserra Júnior, J.E.A.; de Carvalho, C.P.; Eberlin, M.N.; Porcari, A.M.; et al. Endophytic Trichoderma strains isolated from forest species of the Cerrado-Caatinga ecotone are potential biocontrol agents against crop pathogenic fungi. PLoS ONE 2022, 17, e0265824. [Google Scholar] [CrossRef] [PubMed]
- Admasu, W.; Sintayehu, A.; Gezahgne, A.; Terefework, Z. In vitro bioefficacy of Trichoderma species against two Botryosphaeriaceae fungi causing Eucalyptus stem canker disease in Ethiopia. J. Nat. Pestic Res. 2023, 4, 100037. [Google Scholar] [CrossRef]
- Bedine, M.A.B.; Taïeb, N.; Agriopoulou, S.; Miché, L.; Moussango, D.; Sameza, M.L.; Dupuy, N.; Roussos, S.; Fekam Boyom, F. Identification of native soil-derived Trichoderma spp. isolates and analysis of their antagonist traits against Lasiodiplodia theobromae causing stem-end rot in papaya. Arch. Phytopathol. Plant Prot. 2022, 55, 1766–1794. [Google Scholar] [CrossRef]
- Marraschi, R.; Ferreira, A.B.M.; Da Silva Bueno, R.N.; Leite, J.A.B.P.; Lucon, C.M.M.; Harakava, R.; Leite, L.G.; Padovani, C.R.; Bueno, C.J. A protocol for selection of Trichoderma spp. to protect grapevine pruning wounds against Lasiodiplodia theobromae. Braz. J. Microbiol. 2019, 50, 213–221. [Google Scholar] [CrossRef]
- Kalimutu, P.K.; Mahardika, I.B.K.; Sagung, P.R.A.A.A. Antagonism test of Trichoderma atroviride and Gliocladium sp. Bali local isolates as a disease control of Blendok Disease (Botryodiplodia theobromae) in grapefruit (Citrus grandis L. Osbeck). Sustain. Environ. Agric. Sci. 2020, 4, 102–110. [Google Scholar] [CrossRef]

| Strains | Mycelia Color |
|---|---|
| S-P01 | White hyphae turned dark gray |
| S-P02 | White hyphae turned dark gray |
| S-P03 | White hyphae turned totally dark gray on the dish |
| S-P04 | White hyphae turned grayish-black and were lighter from the border to the center of the dish, with many fungal blocks |
| S-P05 | White hyphae turned unevenly grayish-black |
| S-P06 | White hyphae turned grayish-black and were lighter from the border to the center of the dish, with many fungal blocks |
| S-P07 | White hyphae turned grayish-black alternatively from the border to the center of the dish, with many fungal blocks |
| S-P08 | White hyphae turned unevenly grayish-black |
| S-P09 | White hyphae turned dark gray |
| S-P10 | White hyphae turned totally dark gray on the dish |
| S-P11 | White hyphae turned dark gray |
| Strains | Mycelial Length of Fungal Pathogen Grown on the Medium after Transferring (cm) | ||
|---|---|---|---|
| 24 h | 48 h | 72 h | |
| S-P01 | 3.10 f | 4.57 f | 6.10 h |
| S-P02 | 2.63 g | 5.27 e | 7.40 f |
| S-P03 | 4.00 c | 5.60 d | 8.00 c |
| S-P04 | 4.17 bc | 6.13 bc | 8.37 b |
| S-P05 | 3.57 e | 5.60 d | 7.60 e |
| S-P06 | 4.40 b | 6.37 b | 8.67 a |
| S-P07 | 4.67 a | 7.10 a | 8.77 a |
| S-P08 | 4.03 c | 6.13 bc | 7.80 d |
| S-P09 | 1.07 h | 2.63 g | 5.33 i |
| S-P10 | 3.73 de | 5.73 d | 7.20 g |
| S-P11 | 3.97 cd | 6.03 c | 8.30 b |
| Level of significance | * | * | * |
| CV (%) | 4.10 | 2.47 | 1.80 |
| Fungal Pathogen | Time for the Symptom to Appear (DAI) | Time of Whole Fruit Rot (DAI) | Diameter of Fruit Rot (cm) |
|---|---|---|---|
| S-P06 | 7 | 15 | 1.25 |
| S-P07 | 6 | 12 | 1.05 |
| Control | No fruit rot | No fruit rot | No fruit rot |
| No. | Strains | Antagonistic Efficiency (%) | Diameter of Antagonism against L. theobromae S-P06 (cm) | ||
|---|---|---|---|---|---|
| 48 h | 72 h | 48 h | 72 h | ||
| 1 | T-SP01 | 22.5 bc | 52.2 f–k | 2.47 a ± 0.06 | 2.07 b–f ± 0.06 |
| 2 | T-SP02 | 20.8 bc | 54.0 c–i | 2.53 a ± 0.0 | 2.00 c–g ± 0.15 |
| 3 | T-SP03 | 22.9 bc | 52.3 f–k | 2.47 a ± 0.06 | 2.07 b–f ± 0.12 |
| 4 | T-SP04 | 20.8 bc | 56.1 b–g | 2.53 a ± 0.06 | 1.90 f–j ± 0.12 |
| 5 | T-SP05 | 21.9 bc | 53.2 d–j | 2.50 a ± 0.10 | 2.03 b–g ± 0.10 |
| 6 | T-SP06 | 22.5 bc | 48.6 jk | 2.47 a ± 0.06 | 2.23 ab ± 0.12 |
| 7 | T-SP07 | 20.4 bc | 50.2 ijk | 2.53 a ± 0.06 | 2.17 a–d ± 0.06 |
| 8 | T-SP08 | 19.8 bc | 53.3 d–j | 2.57 a ± 0.06 | 2.03 b–g ± 0.12 |
| 9 | T-SP09 | 22.9 bc | 56.3 b–f | 2.47 a ± 0.10 | 1.90 f–j ± 0.06 |
| 10 | T-SP10 | 19.4 bc | 50.2 i–k | 2.57 a ± 0.06 | 2.17 a–d ± 0.15 |
| 11 | T-SP11 | 22.1 bc | 55.7 b–g | 2.47 a ± 0.06 | 1.93 e–i ± 0.10 |
| 12 | T-SP12 | 20.6 bc | 55.7 b–g | 2.50 a ± 0.06 | 1.93 e–i ± 0.15 |
| 13 | T-SP13 | 21.0 bc | 52.9 e–j | 2.50 a ± 0.06 | 2.03 b–g ± 0.06 |
| 14 | T-SP14 | 21.7 bc | 55.2 b–h | 2.47 a ± 0.10 | 1.93 e–i ± 0.10 |
| 15 | T-SP15 | 20.0 bc | 56.0 b–g | 2.53 a ± 0.06 | 1.90 f–j ± 0.06 |
| 16 | T-SP16 | 22.9 bc | 54.0 c–i | 2.47 a ± 0.06 | 2.00 c–g ± 0.06 |
| 17 | T-SP17 | 22.5 bc | 57.8 b–d | 2.47 a ± 0.06 | 1.83 h–j ± 0.12 |
| 18 | T-SP18 | 20.0 bc | 59.4 b | 2.53 a ± 0.06 | 1.77 i ± 0.10 |
| 19 | T-SP19 | 50.8a | 86.2 a | 1.57 b ± 0.10 | 0.60 j ± 0.06 |
| 20 | T-SP20 | 21.3 bc | 52.1 f–k | 2.47 a ± 0.06 | 2.07 b–f ± 0.12 |
| 21 | T-SP21 | 21.5 bc | 49.8 ijk | 2.50 a ± 0.06 | 2.17 a–d ± 0.12 |
| 22 | T-SP22 | 18.1c | 54.4 c–i | 2.57 a ± 0.15 | 1.97 d–h ± 0.12 |
| 23 | T-SP23 | 21.9 bc | 52.1 f–k | 2.50 a ± 0.15 | 2.07 b–f ± 0.06 |
| 24 | T-SP24 | 22.9 bc | 52.7 e–j | 2.47 a ± 0.06 | 2.03 b–g ± 0.06 |
| 25 | T-SP25 | 19.0 bc | 50.4 h–k | 2.57 a ± 0.15 | 2.13 a–e ± 0.15 |
| 26 | T-SP26 | 21.1 bc | 57.5 b–e | 2.50 a ± 0.06 | 1.83 h–j ± 0.06 |
| 27 | T-SP27 | 21.4 bc | 51.3 g–k | 2.50 a ± 0.10 | 2.10 a–f ± 0.10 |
| 28 | T-SP28 | 22.1 bc | 52.9 e–j | 2.47 a ± 0.06 | 2.03 b–g ± 0.10 |
| 29 | T-SP29 | 20.4 bc | 49.0 jk | 2.53 a ± 0.06 | 2.20 a–c ± 0.12 |
| 30 | T-SP30 | 21.1 bc | 52.1 f–k | 2.50 a ± 0.06 | 2.07 b–f ± 0.15 |
| 31 | T-SP31 | 22.1 bc | 47.9 k | 2.47 a ± 0.06 | 2.27 a ± 0.12 |
| 32 | T-SP32 | 48.7a | 85.4 a | 1.63 b ± 0.10 | 0.63 j ± 0.15 |
| 33 | T-SP33 | 22.5 bc | 49.6 i–k | 2.47 a ± 0.12 | 2.17 a–d ± 0.15 |
| 34 | T-SP34 | 20.0 bc | 50.4 h–k | 2.53 a ± 0.15 | 2.13 a–e ± 0.12 |
| 35 | T-SP35 | 22.1 bc | 54.3 c–i | 2.47 a ± 0.06 | 1.97 d–h ± 0.10 |
| 36 | T-SP36 | 20.6 bc | 58.3 b c | 2.50 a ± 0.17 | 1.80 hi ± 0.15 |
| 37 | T-SP37 | 22.1 bc | 52.9 e–j | 2.47 a ± 0.06 | 2.03 b–g ± 0.10 |
| 38 | T-SP38 | 22.5 bc | 51.3 g–k | 2.47 a ± 0.15 | 2.10 a–f ± 0.15 |
| 39 | T-SP39 | 19.4 bc | 52.1 f–k | 2.57 a ± 0.17 | 2.07 b–f ± 0.15 |
| 40 | T-SP40 | 21.9 bc | 50.6 h–k | 2.50 a ± 0.12 | 2.13 a–e ± 0.12 |
| 41 | T-SP41 | 24.0 bc | 52.9 e–j | 2.43 a ± 0.06 | 2.03 b–g ± 0.12 |
| 42 | T-SP42 | 21.9 bc | 55.2 b–h | 2.50 a ± 0.12 | 1.93 e–i ± 0.12 |
| 43 | T-SP43 | 19.0 bc | 54.4 c–i | 2.57 a ± 0.15 | 1.97 d–h ± 0.15 |
| 44 | T-SP44 | 22.1 bc | 52.1 f–k | 2.47 a ± 0.12 | 2.07 b–f ± 0.10 |
| 45 | T-SP45 | 20.8 bc | 52.1 f–k | 2.53 a ± 0.06 | 2.07 b–f ± 0.10 |
| 46 | T-SP46 | 24.0 bc | 53.5 d–j | 2.43 a ± 0.06 | 2.00 c–g ± 0.06 |
| 47 | T-SP47 | 22.9 bc | 52.7 e–j | 2.47 a ± 0.15 | 2.03 b–g ± 0.12 |
| 48 | T-SP48 | 20.0 bc | 49.6 i–k | 2.53 a ± 0.12 | 2.17 a–d ± 0.15 |
| 49 | T-SP49 | 22.1 bc | 52.7 e–j | 2.47 a ± 0.06 | 2.03 b–g ± 0.12 |
| 50 | T-SP50 | 22.1 bc | 52.7 e–j | 2.47 a ± 0.12 | 2.03 b–g ± 0.12 |
| F | * | * | * | * | |
| CV (%) | 11.3 | 4.43 | 2.8 | 5.01 | |
| No. | Strains | Antagonistic Efficiency (%) | Diameter of Antagonism against L. theobromae S-P07 (cm) | ||
|---|---|---|---|---|---|
| 48 h | 72 h | 48 h | 72 h | ||
| 1 | T-SP01 | 22.5 b–d | 50.4 k–n | 2.47 ab ± 0.10 | 2.17 a–c ± 0.10 |
| 2 | T-SP02 | 20.8 cd | 54.8 d–j | 2.53 a ± 0.06 | 1.97 d–g ± 0.15 |
| 3 | T-SP03 | 22.9 b–d | 52.3 f–n | 2.47 ab ± 0.10 | 2.07 a–e ± 0.12 |
| 4 | T-SP04 | 27.0 b | 55.4 d–g | 2.33 b ± 0.06 | 1.93 e–g ± 0.12 |
| 5 | T-SP05 | 21.9 b–d | 54.7 d–k | 2.50 a ± 0.10 | 1.97 d–g ± 0.10 |
| 6 | T-SP06 | 22.5 b–d | 48.6 n | 2.47 ab ± 0.15 | 2.23 a ± 0.15 |
| 7 | T-SP07 | 20.4 cd | 51.0 h–n | 2.53 a ± 0.10 | 2.13 a–d ± 0.10 |
| 8 | T-SP08 | 19.8 cd | 54.8 e–i | 2.57 a ± 0.15 | 1.97 d–g ± 0.10 |
| 9 | T-SP09 | 22.9 b–d | 54.8 d–j | 2.47 ab ± 0.10 | 1.97 d–g ± 0.15 |
| 10 | T-SP10 | 19.4 cd | 51.7 f–n | 2.57 a ± 0.10 | 2.10 a–e ± 0.06 |
| 11 | T-SP11 | 22.1 b–d | 54.2 e–k | 2.47 ab ± 0.10 | 2.00 c–f ± 0.06 |
| 12 | T-SP12 | 20.6 cd | 55.7 c–f | 2.50 a ± 0.06 | 1.93 efg ± 0.06 |
| 13 | T-SP13 | 21.0 cd | 52.1 f–n | 2.50 a ± 0.10 | 2.07 a–e ± 0.12 |
| 14 | T-SP14 | 21.7 cd | 54.4 e–k | 2.47 ab ± 0.15 | 1.97 d–g ± 0.10 |
| 15 | T-SP15 | 20.0 cd | 55.2 d–h | 2.5 a ± 0.10 | 1.93 e–g ± 0.12 |
| 16 | T-SP16 | 22.9 b–d | 53.2 f–m | 2.47 ab ± 0.10 | 2.03 b–e ± 0.06 |
| 17 | T-SP17 | 22.5 b–d | 58.6 cd | 2.47 ab ± 0.15 | 1.80 gh ± 0.06 |
| 18 | T-SP18 | 20.0 cd | 62.4 b | 2.53 a ± 0.06 | 1.63 i ± 0.06 |
| 19 | T-SP19 | 49.8 a | 85.4 a | 1.60 c ± 0.15 | 0.63 j ± 0.15 |
| 20 | T-SP20 | 21.3 cd | 52.9 f–n | 2.47 ab ± 0.15 | 2.03 b–e ± 0.10 |
| 21 | T-SP21 | 21.5 cd | 51.4 f–n | 2.50 a ± 0.10 | 2.10 a–e ± 0.06 |
| 22 | T-SP22 | 18.1 d | 54.4 e-k | 2.57 a ± 0.06 | 1.97 d–g ± 0.10 |
| 23 | T-SP23 | 21.9 b–d | 52.1 f–n | 2.50 a ± 0.06 | 2.07 a–e ± 0.10 |
| 24 | T-SP24 | 22.9 b–d | 53.5 e-l | 2.47 ab ± 0.12 | 2.00 c–f ± 0.12 |
| 25 | T-SP25 | 19.0 cd | 50.4 j-n | 2.57 a ± 0.06 | 2.13 a–d ± 0.12 |
| 26 | T-SP26 | 21.1 cd | 57.5 c–e | 2.50 a ± 0.10 | 1.83 f–h ± 0.10 |
| 27 | T-SP27 | 21.4 cd | 51.3 f–n | 2.50 a ± 0.10 | 2.10 a–e ± 0.15 |
| 28 | T-SP28 | 22.1 b–d | 52.9 f–n | 2.47 ab ± 0.10 | 2.03 b–e ± 0.06 |
| 29 | T-SP29 | 20.4 cd | 49.0 mn | 2.53 a ± 0.10 | 2.20 ab ± 0.12 |
| 30 | T-SP30 | 21.1 cd | 52.9 f–n | 2.50 a ± 0.15 | 2.03 b–e ± 0.15 |
| 31 | T-SP31 | 22.1 b–d | 51.3 f–n | 2.47 ab ± 0.06 | 2.10 a–e ± 0.15 |
| 32 | T-SP32 | 47.6 a | 84.7 a | 1.67 c ± 0.10 | 0.67 j ± 0.15 |
| 33 | T-SP33 | 22.5 b–d | 51.2 g–n | 2.47 ab ± 0.12 | 2.10 a–e ± 0.12 |
| 34 | T-SP34 | 20.0 cd | 50.4 j-n | 2.53 a ± 0.06 | 2.13 a–d ± 0.06 |
| 35 | T-SP35 | 22.1 b–d | 54.2 e-k | 2.47 ab ± 0.10 | 1.97 d–g ± 0.12 |
| 36 | T-SP36 | 20.6 cd | 59.4 bc | 2.50 a ± 0.06 | 1.77 hi ± 0.12 |
| 37 | T-SP37 | 22.1 b–d | 52.9 f–n | 2.47 ab ± 0.06 | 2.03 b–e ± 0.06 |
| 38 | T-SP38 | 22.5 b–d | 51.3 f–n | 2.47 ab ± 0.06 | 2.10 a–e ± 0.12 |
| 39 | T-SP39 | 19.4 cd | 52.1 f–n | 2.57 a ± 0.10 | 2.07 a–e ± 0.12 |
| 40 | T-SP40 | 21.9 b–d | 50.6 i–n | 2.50 a ± 0.06 | 2.13 a–d ± 0.06 |
| 41 | T-SP41 | 24.0 bc | 52.9 f–n | 2.43 ab ± 0.10 | 2.03 b–e ± 0.10 |
| 42 | T-SP42 | 21.9 b–d | 55.2 d–h | 2.50 a ± 0.10 | 1.93 e–g ± 0.12 |
| 43 | T-SP43 | 19.0 cd | 52.5 f–n | 2.57 a ± 0.10 | 2.07 a–e ± 0.15 |
| 44 | T-SP44 | 22.1 b–d | 52.9 f–n | 2.47 ab ± 0.15 | 2.03 b–e ± 0.10 |
| 45 | T-SP45 | 20.8 cd | 52.1 f–n | 2.53 a ± 0.06 | 2.07 a–e ± 0.02 |
| 46 | T-SP46 | 24.0 bc | 53.5 e–l | 2.43 ab ± 0.10 | 2.00 c–f ± 0.12 |
| 47 | T-SP47 | 22.9 b–d | 52.7 f–n | 2.47 ab ± 0.10 | 2.03 b–e ± 0.06 |
| 48 | T-SP48 | 20.0 cd | 49.6 l–n | 2.53 a ± 0.06 | 2.17 a–c ± 0.10 |
| 49 | T-SP49 | 22.1 b–d | 52.7 f–n | 2.47 ab ± 0.15 | 2.03 b–e ± 0.10 |
| 50 | T-SP50 | 22.1 b–d | 52.7 f–n | 2.47 ab ± 0.10 | 2.03 b–e ± 0.15 |
| F | * | * | * | * | |
| CV (%) | 11.4 | 3.90 | 2.80 | 4.54 | |
Disclaimer/Publisher’s Note: The statements, opinions and data contained in all publications are solely those of the individual author(s) and contributor(s) and not of MDPI and/or the editor(s). MDPI and/or the editor(s) disclaim responsibility for any injury to people or property resulting from any ideas, methods, instructions or products referred to in the content. |
© 2023 by the authors. Licensee MDPI, Basel, Switzerland. This article is an open access article distributed under the terms and conditions of the Creative Commons Attribution (CC BY) license (https://creativecommons.org/licenses/by/4.0/).
Share and Cite
Khuong, N.Q.; Nhien, D.B.; Thu, L.T.M.; Trong, N.D.; Hiep, P.C.; Thuan, V.M.; Quang, L.T.; Thuc, L.V.; Xuan, D.T. Using Trichoderma asperellum to Antagonize Lasiodiplodia theobromae Causing Stem-End Rot Disease on Pomelo (Citrus maxima). J. Fungi 2023, 9, 981. https://doi.org/10.3390/jof9100981
Khuong NQ, Nhien DB, Thu LTM, Trong ND, Hiep PC, Thuan VM, Quang LT, Thuc LV, Xuan DT. Using Trichoderma asperellum to Antagonize Lasiodiplodia theobromae Causing Stem-End Rot Disease on Pomelo (Citrus maxima). Journal of Fungi. 2023; 9(10):981. https://doi.org/10.3390/jof9100981
Chicago/Turabian StyleKhuong, Nguyen Quoc, Dinh Bich Nhien, Le Thi My Thu, Nguyen Duc Trong, Phan Chan Hiep, Vo Minh Thuan, Le Thanh Quang, Le Vinh Thuc, and Do Thi Xuan. 2023. "Using Trichoderma asperellum to Antagonize Lasiodiplodia theobromae Causing Stem-End Rot Disease on Pomelo (Citrus maxima)" Journal of Fungi 9, no. 10: 981. https://doi.org/10.3390/jof9100981
APA StyleKhuong, N. Q., Nhien, D. B., Thu, L. T. M., Trong, N. D., Hiep, P. C., Thuan, V. M., Quang, L. T., Thuc, L. V., & Xuan, D. T. (2023). Using Trichoderma asperellum to Antagonize Lasiodiplodia theobromae Causing Stem-End Rot Disease on Pomelo (Citrus maxima). Journal of Fungi, 9(10), 981. https://doi.org/10.3390/jof9100981

